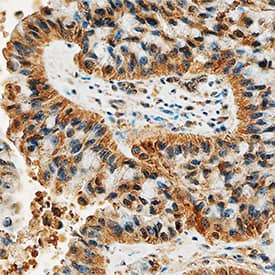
DDR2 antibody in Human Lung Cancer Tissue by Immunohistochemistry (IHC-P).

Human DDR2 Antibody
R&D Systems, part of Bio-Techne | Catalog # MAB25381


Key Product Details
Species Reactivity
Validated:
Cited:
Applications
Validated:
Cited:
Label
Antibody Source
Product Specifications
Immunogen
Gln24-Arg399
Accession # Q16832
Specificity
Clonality
Host
Isotype
Scientific Data Images for Human DDR2 Antibody
Detection of Human DDR2 in HEK293 Human Cell Line
HEK293 human embryonic kidney cell line transfected with human DDR2 and Enhanced Green Fluorescent Protein (eGFP) was stained with either (A) Mouse IgG2BIsotype Control (Catalog # MAB00401) or (B) Mouse Anti-Human DDR2 Monoclonal Antibody (Catalog # MAB25381) followed by Allophycocyanin-conjugated Anti-Mouse IgG Secondary Antibody (Catalog # F0101B).DDR2 in Human Lung Cancer Tissue.
DDR2 was detected in immersion fixed paraffin-embedded sections of human lung cancer tissue using Mouse Anti-Human DDR2 Monoclonal Antibody (Catalog # MAB25381) at 15 µg/mL overnight at 4 °C. Tissue was stained using the Anti-Mouse HRP-DAB Cell & Tissue Staining Kit (brown; Catalog # CTS002) and counterstained with hematoxylin (blue). Specific staining was localized to cytoplasm. View our protocol for Chromogenic IHC Staining of Paraffin-embedded Tissue Sections.Applications for Human DDR2 Antibody
CyTOF-reported
Flow Cytometry
Sample: HEK293 human embryonic kidney cell line transfected with human DDR2 and Enhanced Green Fluorescent Protein (eGFP)
Immunohistochemistry
Sample: Immersion fixed paraffin-embedded sections of human lung cancer tissue
Formulation, Preparation, and Storage
Purification
Reconstitution
Formulation
Shipping
Stability & Storage
- 12 months from date of receipt, -20 to -70 °C as supplied.
- 1 month, 2 to 8 °C under sterile conditions after reconstitution.
- 6 months, -20 to -70 °C under sterile conditions after reconstitution.
Background: DDR2
DDR2, also known as TYR010 and TKT, is a widely expressed 130 kDa type I transmembrane glycoprotein belonging to the discoidin-like domain containing subfamily of receptor tyrosine kinases (1). Mature human DDR2 consists of a 378 amino acid (aa) extracellular domain (ECD) that includes the discoidin-like domain, a 22 aa transmembrane segment, and a 434 aa cytoplasmic domain that includes the kinase domain (2). Within the ECD, human DDR2 shares 53% aa sequence identity with DDR1 and 97% aa sequence identity with mouse DDR2. The discoidin-like domain mediates DDR2 interactions with collagens I, III, and X (3‑5). Collagens II and V are less efficacious ligands (3). DDR2 selectively recognizes the triple helical structure of collagen compared to monomeric or denatured collagen (3, 5, 6). Within collagen II, the D2 period is required for DDR2 binding, and the D1 period is additionally required to trigger DDR2 autophosphorylation (6). The ECD of DDR2 exists as a non-covalent dimer in solution, and dimerization of the receptor greatly enhances collagen binding (4, 7). DDR2 interaction with collagen I inhibits collagen fibrillogenesis and alters collagen fiber morphology (7). Ligand binding induces DDR2 autophosphorylation in the cytoplasmic domain (3, 5, 8), which promotes associations with Shc and Src (9). In addition to the above mechanism, DDR2 exhibits a distinct interaction with collagen X. A region other than the discoidin-like domain of DDR2 recognizes the non-helical NC1 domain of collagen X, and this interaction does not lead to receptor autophosphorylation (5). Activation of DDR2 by collagen induces upregulation of MMP-1, -2, and -13 as well as DDR2 itself (3, 8, 10). DDR2 is implicated in collagenous matrix destruction and cell invasiveness (8, 10). DDR2 is also upregulated in several pathological conditions, including hepatic fibrosis following injury, rheumatoid and osteoarthritis, and smooth muscle cell hyperplasia (8, 10‑12).
References
- Vogel, W.F. et al. (2006) Cell. Signal. 18:1108.
- Karn, T. et al. (1993) Oncogene 8:3433.
- Vogel, W. et al. (1997) Mol. Cell 1:13.
- Leitinger, B. (2003) J. Biol. Chem. 278:16761.
- Leitinger, B. and A.P.L Kwan (2006) Matrix Biol. 25:355.
- Leitinger, B. et al. (2004) J. Mol. Biol. 344:993.
- Mihai, C. et al. (2006) J. Mol. Biol. 361:864.
- Olaso, E. et al. (2001) J. Clin. Invest. 108:1369.
- Ikeda, K. et al. (2002) J. Biol. Chem. 277:19206.
- Xu, L. et al. (2005) J. Biol. Chem. 280:548.
- Wang, J. et al. (2002) J. Autoimmun. 19:161.
- Ferri, N. et al. (2004) Am. J. Pathol. 164:1575.
Long Name
Alternate Names
Gene Symbol
UniProt
Additional DDR2 Products
Product Documents for Human DDR2 Antibody
Product Specific Notices for Human DDR2 Antibody
For research use only